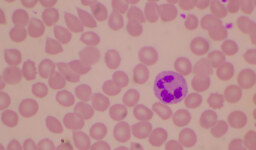

Amniyosentez testi, hamilelik sırasında bebeğin sağlığını kontrol etmek ve olası genetik hastalıkları tespit etmek amacıyla yapılan önemli bir prenatol testtir. Bu test, anne karnındaki bebeğin sağlık durumu hakkında kritik bilgiler sağlayarak, özellikle belirli risk gruplarındaki hamile kadınlar için önerilir. Testin amacı, bebekte var olabilecek genetik ya da kromozomal bozuklukları erkenden belirlemektir. Örneğin, Down sendromu gibi kromozom kaynaklı hastalıklar ile diğer genetik anomaliler bu yolla tespit edilebilir. Sonuç olarak, amniyosentez testi farklı sağlık durumlarını önceden teşhis etme potansiyeline sahiptir. Bu yazıda amniyosentez testi ile ilgili bilmeniz gerekenleri inceleyeceğiz ve testin önemi, yapılış şekli ve yaygın olarak ne zaman yapıldığı hakkında bilgi vereceğiz. Tüm bu bilgiler, anne adaylarının bilinçli seçimler yapmasına yardımcı olabilir.
Amniyosentez Testi Nedir?
Amniyosentez testi, anne karnındaki bebeğin amniyotik sıvısından örnek alarak genetik ve bulaşıcı hastalıklar dahil birçok potansiyel sağlık sorununu değerlendirmek için kullanılan önemli bir prenatal testtir. Genellikle, Down sendromu gibi kromozom bozukluklarını tespit etmek için uygulanır. Aynı zamanda cinsiyet belirleme gibi ek bilgiler sunabilir. Anne adayları için, ailede kalıtsal hastalık öyküsü veya önceki hamileliklerde genetik bozukluk tespiti durumunda özellikle önerilmektedir. Testin başarılı bir sonuç vermesi için doğru zamanlamada ve uzman kişiler tarafından yapılması hayati öneme sahiptir.
Amniyosentez Testi Nasıl ve Ne Zaman Yapılır?
Amniyosentez Nasıl Yapılır sorusu birçok anne adayının merakını uyandırabilir. İşlem sırasında, bir doktor ultrason eşliğinde karından ince bir iğne ile amniyon kesesine girerek amniyotik sıvı örneği alır. Bu, bebeğin sağlık durumunu değerlendirmek için kritik öneme sahiptir. İşlem, steril bir ortamda dikkatli bir şekilde gerçekleştirilir ve genellikle 15-30 dakika kadar sürer. İşlem genellikle ağrısızdır, ancak çeşitli hafif rahatsızlık veya kramp hissedilebilir. Uzman bir ekip tarafından yapılan bu işlemde, vücutta olası rahatsızlıkları minimize etmek için en yüksek özen gösterilir. Öncesinde doktorunuzla detaylı bir görüşme yaparak, işlem hakkında tüm bilgileri elde edebilirsiniz. Amniyosentez yapıldıktan sonra, doktorlar genellikle bir süre dinlenmenizi tavsiye eder.
Genellikle gebeliğin 15. ve 20. haftaları arasında yapılır. Bu haftalar, bebeğin gelişimi ve genetik yapısı hakkında daha kesin ve güvenilir sonuçlar elde edilebilmesi için en uygun dönemdir. Bu süre zarfında yapılacak testler, bebekte herhangi bir genetik anomali olup olmadığını değerlendirmek için daha doğru bilgiler sağlar. Uzmanlar, bu süreci en doğru şekilde değerlendirmek ve sonuçları optimize etmek için belirlemişlerdir. Daha erken veya daha geç yapılması önerilmez, çünkü sonuçların doğruluğunu etkileyebilir.
Amniyosentez Yapılmasının Riskleri
Amniyosentez riskleri, her tıbbi prosedürde olduğu gibi vardır. Ancak, deneyimli profesyoneller tarafından yapıldığında, ciddi komplikasyonlar oldukça nadirdir. En yaygın riskler arasında düşük, enfeksiyon ve amniyotik sıvı sızıntısı yer alır. Aynı zamanda, işlem sonrasında rahatsızlık veya kramplar da oluşabilir, fakat genellikle kendiliğinden geçer. Bazı durumlarda, kanama veya karın ağrısı yaşanabilir; bu nedenle, hastalar prosedür sonrası anormal bir durumla karşılaştıklarında dikkatli olmalı ve doktorlarıyla iletişime geçmelidir. Doktorlar, bu riskleri minimumda tutmak için her türlü özeni gösterirler ve gelişen teknoloji ile ortaya çıkabilecek komplikasyonlar daha da azaltılmıştır.
Amniyosentez Testinin Avantajları
- Down sendromu ve diğer kromozomal anomalilerin erken tespiti. Bu sayede, ebeveynler uygun planlama ve hazırlık yaparak gerekli önlemleri alabilirler.
- Bebeğin gelişim sorunlarının ve nöral tüp defektlerinin tanısı. Bu erken tanı, uzmanların etkin bir tedavi planı oluşturmasına olanak tanır ve bebeğin sağlıklı gelişimine katkı sağlar.
- Doğum öncesi oluşabilecek sağlık sorunlarına erken müdahale şansı. Bu durum, bebeğin yaşam kalitesini olumlu yönde etkileyebilir ve olası komplikasyonların önüne geçilebilir.
Amniyosentez genellikle ileri yaşta gebelik yaşayanlar, daha önce genetik hastalık öyküsü olanlar veya tarama testlerinde riskli sonuçlar alınan gebeler için önerilir. Doktor değerlendirmesiyle kişiye özel olarak karar verilir.
Test sonrasında hafif kramplar ve rahatsızlık hissi oluşabilir. Dinlenmek, ağır kaldırmamak ve doktorun önerilerini takip etmek önemlidir. Şüpheli bir durum oluşursa, mutlaka sağlık uzmanıyla iletişime geçilmelidir.
Amniyosentez testi uzman bir ekip tarafından yapıldığında risk oranı oldukça düşüktür. Nadir de olsa düşük, enfeksiyon veya sıvı sızıntısı gibi komplikasyonlar oluşabilir. Bu nedenle işlem öncesi ve sonrası doktor gözetimi esastır.